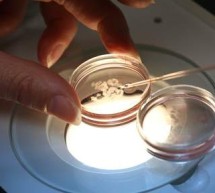

ÇFARË VAJI TË ZGJEDHIM NË BAZË TË TIPIT TË LËKURËS, (II)
© Lorena Stroka Përshëndetje të gjithëve! Epo nuk thotë kot populli: "Mukajeti të lë pa martuar!" :D Kështu edhe kjo puna ime! Edhe pse në stick kam një 'mal' shkrimesh të përgatitura, kur vjen koha për t'i postuar, çuditërisht, bëhem aq përtace sa nis justifikimet: hë se po s'munde sot, ditë është dhe nesër... E disi kështu nga shtyrja për një ditë, kalojmë në atë për një vit! Nejse për të mos ju lodhur më ...
Read more ›